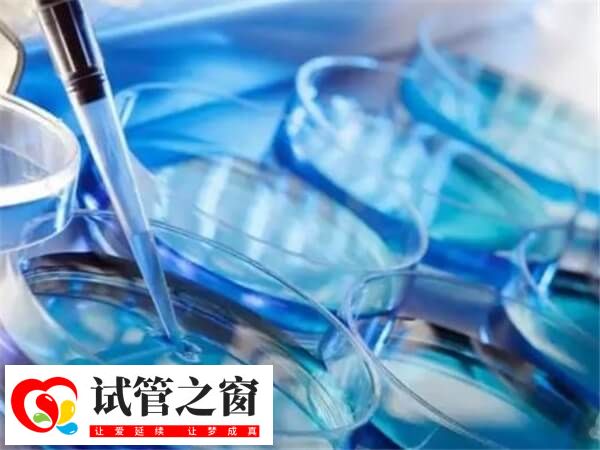
閉經后做試管嬰兒得看情況

女性閉經后能不能做試管嬰兒
女性閉經以后也有很多是可以做試管嬰兒的,閉經發生在絕經年齡前,首先尋找引起閉經的原因,有些人是因為內分泌失調,比如多囊卵巢綜合征、高泌乳素血癥或者精神壓力過大、身體肥胖等一些因素導致的,就可以進行相關的檢查與治療,調整月經周期,促排卵再備孕,備孕失敗也可以嘗試試管嬰兒。
閉經后做試管嬰兒
閉經能否做試管
試管嬰兒能否成功,關鍵要看女性體內是否還有卵子提供,也就是說,女性在閉經之后是否能做試管嬰兒要分兩種情況:
1、自然閉經
隨著年齡的不斷增長,人體也會無可避免的進入衰老的狀態,而閉經也是主要的一個特性。在自然狀態下閉經的情況,一般而言就是子宮已經進入了自然衰老的狀態,因此也不會再有卵子的排出,試管嬰兒自然也就沒有了卵子來和精子結合。
即使有極少數短時間的閉經期內女性還會有卵子排出的情況,但通常卵子的質量都非常低,孕育成功的幾率非常小。而且自然閉經的情況下,子宮也隨著雌孕激素的減少而逐漸衰退,變得不再適合胎兒的生長。
2、病理性閉經
比如長期的月經不調、內分泌失調、子宮肌腺癥以及其他婦科疾病都有可能引發閉經。對于病理性閉經,最根本是要了解造成閉經的原因,再進行針對性的治療,并且保證治療對于子宮、卵巢、輸卵管沒有造成過分刺激,調理好身體后就可以進行試管嬰兒治療。這樣的治療方式更加有利于提高試管嬰兒的成功率。
女性最晚生育年齡
正常來說,女性的最佳生育年齡在23-30歲之間,這段時間內的寶寶是最健康聰明的。而對于最晚生育年齡,是因每個人的身體狀況差異有所不同的。有人在40歲以上就很難生育,卻也有人50多歲都還能生育。據目前資料顯示,我國年齡最高的產婦為64歲,不過從醫學角度來說,45歲以上就不建議繼續生育了。





